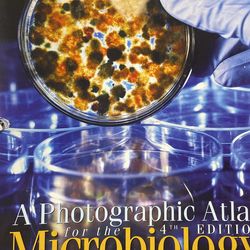

Seller profile
Nadia
Joined Oct 2015
Whittier, CA
(50) offer up reviews
Seller statistics
28
Bought
69
Sold
24
Followers
Badges
Responds in a few minutes
Active in the last day
- 100% reply rate
- Confirmed Facebook
- Confirmed email
Compliments
- 11 Item as described compliments
- 26 Friendly compliments
- 24 On time compliments
- 23 Communicative compliments
- 24 Reliable compliments